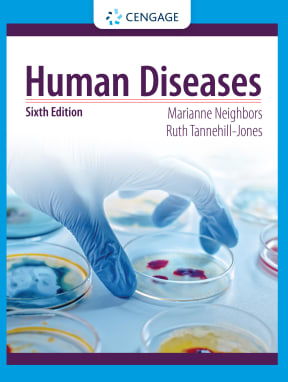
9781317695745.jpg

Human Diseases 6th edition – Original PDF
$29.99
| Author | Marianne Neighbors, Ruth Tannehill-Jones |
|---|---|
| Publisher | CENGAGE Learning (5/5/2022) |
| Format | Format PDF |
Caution: You’re about to purchase a high quality copy (no missing contents), NOT a Paper Book, Access Code or Audiobook! It can be printed, stored and read on any devices.
==> The download link will be automatically sent to your email immediately after purchase.